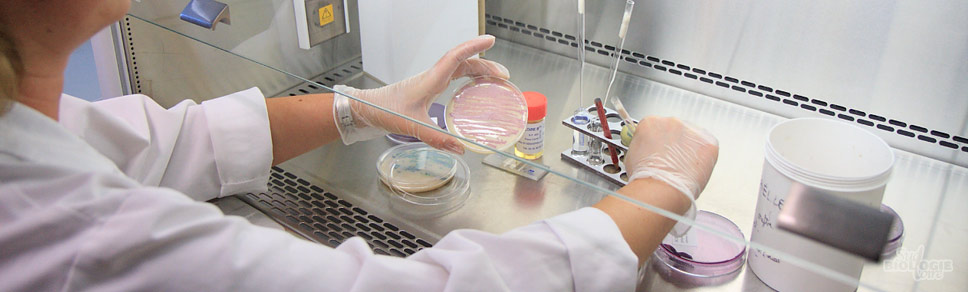
laboratoire-biologie-medicale-test-bacterien

Qu’est-ce que l’HGH ?
L’hormone de croissance, somatotropine de son vrai nom, est une hormone polypeptidique secrétée par les cellules somatotropes de la partie
L’hormone de croissance humaine (HGH – Human Growth Hormone) a des effets « anaboliques ». Elle stimule la croissance et la reproduction cellulaire et agit principalement en se fixant sur un récepteur spécifique.
C’est donc elle qui fait croître les enfants jusque à l’âge adulte. C’est au stade de la puberté, passage de l’état d’enfant à l’état d’adulte que le taux d’hormones de croissance sécrété naturellement atteint son maximum.
Mais l’ HGH n’agit pas que sur les phénomènes de croissance, elle joue aussi un rôle dans la régulation des phénomènes de reproduction aussi bien chez l’homme que la femme.
L’ HGH agit aussi sur le foie et stimule la production d’IGF (Insulin-like growth factor). L’hormone de croissance a une action lipolytique (Brûlure des graisses).
Il n’est donc pas étonnant qu’avec toutes ces propriétés l’HGH soit considérée comme le must des produits dopant.
Que ce soit pour une cure « anti-âge », une augmentation des performances ou un développement rapide de la masse musculaire, l’HGH est LE produit miracle qui répondra à toutes vos attentes.
Quels sont les avantages de l’hormone de croissance ?
C’est principalement le dosage utilisé qui définira les effets perçus avec une cure d’hormone de croissance.
Vous pouvez consulter nos spécialistes pour constituer votre cure idéale .
Parmi ces effets positifs on retrouve :
- Sommeil amélioré: Vous dormirez comme un bébé. Une véritable cure de jouvence.
- Meilleure qualité et texture de votre peau: ceci se remarque particulièrement lorsque vous touchez le dos de votre main. Comparez avec d’autres personnes ou faites y attention avant le début de votre cycle de HGH. Une vraie peau de bébé !
- Accélération du métabolisme: le corps brûle les glucides et la graisse à une rapidité que vous n’aurez jamais vue. Ceci est particulièrement remarquable pendant le cycle initial, quand le corps est surpris par l’augmentation des hormones de croissance et qu’il ne sait d’abord pas comment s’y adapter.
- Augmentation importante de la masse musculaire: les bodybuildeurs remarqueront une augmentation incroyable de leur masse musculaire durant une cure d’HGH, avec l’avantage d’une conservation des bénéfices sur le long-terme.
Et ce n’est pas tout :
Renforcement du système immunitaire, débit cardiaque amélioré, os plus solides, augmentation de la libido, niveau d’énergie revu à la hausse, augmentation de l’endurance et de la performance, récupération accélérée après une activité physique, amélioration de votre profil cholestérol etc etc… La liste est vraiment longue.
Les effets secondaire de l’HGH
Tant que vous respectez les dosages et consommez une HGH de qualité, les effets secondaires sont des plus supportables.
Une cure d’HGH donne souvent l’envie de faire une petite sieste en milieu de journée : mais quand on connait l’effet du sommeil sur votre organisme, on ne va pas s’en plaindre.
Vous pourrez aussi être confronté à ce que l’on appelle « le syndrome du canal carpien ». C’est-à-dire des fourmillements dans les doigts (Cette sensation de la main qui dort après avoir dormi dessus. Ceci est causé par l’augmentation de la masse musculaire dans le poignet qui fait pression sur le canal carpien, à travers duquel passent les nerfs de vos doigts et de votre paume. C’est un effet secondaire temporaire qui disparaîtra complètement).
De hauts dosages peuvent amener des crampes matinales ou une légère rétention d’eau.
Sous HGH, la baisse rapide du taux de sucre dans le sang peut survenir. Surtout après un exercice physique, alors gardez une barre sucrée à portée de main. Cela se manifeste par “crises de faim” et peut durer jusqu’à 2 semaines après la fin de la cure.
Le surdosage sur de longues périodes (ce que nous déconseillons fortement) peut causer un phénomène qui s’appelle « l’acromégalie » (élargissement des doigts, des os, des organes).
Ceci n’arrivera pas avec un dosage normal. Ce phénomène ne se produit qu’en cas de non-respect des posologies.
Comment savoir si mon HGH est de qualité ?
Tout d’abord, il faut se retirer de l’esprit que l’HGH chinoise n’est pas bonne. La qualité du produit est égale aux laboratoires occidentaux.
Pourquoi ?
Tout simplement car c’est de l’hgh, ou bien ce n’en est pas. L’hormone de croissance humaine est une grosse molécule fragile qui comprend 191 acides aminés, liés dans un ordre et une forme bien spécifiques. Pour cette raison, il n’y a pas de place pour les différences !
L’HGH produite au Etats-Unis ou en Europe a un tarif généralement bien plus cher que l’HGH produite en Chine ou à Hong-Kong. Cette différence de prix est démesurée et a pour cause le monopole des grosses multinationales pharmaceutique sur les marchés occidentaux. Le processus de fabrication est donc exactement le même.
La raison pour laquelle les produits chinois sont souvent vus comme de qualité inférieure est la prolifération de la disponibilité de toute copie peu chère (vêtements, appareils électroniques, etc.) qui ont la même apparence que les originaux mais fabriqués avec des matériaux de qualité inférieure et moins durables. Ceci n’est pas possible avec la production de somatropine. Les équipements nécessaires à sa création coûtent à eux seuls plusieurs millions de dollars, alors les laboratoires “baignoires” de stéroïdes ne sont pas capables de la fabriquer.
Comment distinguer la vraie HGH de la fausse HGH?
Il faut tout d’abord que vous évitiez TOUTES HGH comportant 192 amino acid (la Somatrem) qui est en fait une hormone de croissance copiée, comportant des effets indésirables potentiels.
Certains escrocs vendrons aussi de l’HCG (gonadotropin) en vous prétendant que c’est de l’HGH. Pour le vérifier c’est très simple. Une fois le produit dilué, verser le sur un test de grossesse. Celui-ci réagit à l’HCG.
Si vous avez affaire a un produit contaminé, des zébrures rouge, parfois douloureuse peuvent apparaitre dans la zone d’injection. Ceci est souvent provoqué par la Somatrem (192amino acid)
Faites attentions a la plus grande des arnaques sur l’HGH :
Ce produit n’existe pas sous forme de sprays, comprimés ou autre patchs !
L’hormone de croissance est une grosse molécule fragile et instable.
A température ambiante, elle se dégrade en quelques minutes. Elle est aussi très sensible à l’agitation. Des mouvements rapides déformeraient la forme de la molécule, ce qui n’en fera plus du HGH- si elle est déformée, elle ne peut plus s’accrocher aux récepteurs. Alors que la forme liquide du vrai HGH doit être réfrigérée en permanence et manipulée avec soin, les sprays, patchs ou cachets eux, sont gardés à température ambiante, agités, etc.
La molécule de l’hormone de croissance est trop grosse pour passer à travers la peau ou la membrane muqueuse de l’intérieur du nez. Ceci est une autre raison pour laquelle les patchs ne peuvent pas fonctionner.
L’estomac contient de l’acide, qui détruirait le HGH dès qu’il entrerait en contact avec. Voici une autre raison pour laquelle les cachets ne peuvent pas fonctionner.
L’ HGH ne peut pas être produit par les plantes, alors les prétendues HGH naturelles/herbales sont des mensonges marketing.
Quels sont les meilleures HGH du marché et les laboratoires reconnus ?
Voici une liste d’HGH de qualité comportant 191Amico Acid et dont le taux de pureté produit est au maximum. (Pas de contamination ou de vulgaires copies).
- G-TROPIN, 191 amino acid, très haute pureté et fabriqué par Euro Pharmacies.
- Norditropin 191 amino acid, haute pureté et fabriqué par Novo Nordisk (USA)
- Genotropin 191 amino acid, très haute pureté et fabriqué par Pfizer (USA)
Il existe aussi de très bon produits dit « entrée de gamme » à bas prix et qui vous apporterons aussi un bon résultat :
- Hygetropin, 191 amino acid, haute pureté et fabriqué par Hygene biopharm (Chine)
- Ansomone 191 amino acid, haute pureté et fabriqué par Anhui Anke (Chine)
- Jintropin, 191 amino acid, très haute pureté et fabriqué par Genescience (Chine)
Comment doser votre cure d’HGH
En fonction du fabricant, votre vial (flacon) d’HGH peut être dosé différemment. On utilise la mention « UI » ou « IU » ce qui signifie tout simplement « unités injectables ».
Le dosage par flacon peut être 4IU (1.3MG), 10IU (3mg), 12IU (4mg), 40IU (13mg).
Pour une cure anti-âge, le dosage se situe entre 2 et 4IU par jour.
Pour une sèche, le dosage se situera entre 2 et 4IU par jour.
Pour le bodybuilding, le dosage se situe entre 4 et 6IU par jour
Pour un développement musculaire extrême, le dosage sera entre 10 et 16IU sur une courte période (1 mois).
On considère le surdosage à partir de 16IU.
Ces dosages sont bien sur conseillés en étant sur une HGH de qualité telle la G-TROPIN ou autre HGH de qualité pharmacieutique.
Plus votre produit sera douteux, plus important sera votre dosage.
La durée de cure pour l’HGH est de 3 mois minimum. Idéalement 6 mois.
Certaines personnes pensent que l’hormone de croissance doit être utilisée 5 fois par semaine avec une pause de 2 jours en intervalle. Ceci est faux et prend ses origines au moment où le HGH était très cher et que les bodybuildeurs prolongeaient leurs cycles en sautant des jours et en étalant le cycle aussi longtemps qu’ils le pouvaient.
Le corps humain ne fait jamais de pause dans sa production d’hormones de croissance.
Le corps de chaque personne réagit différemment à une cure d’HGH. Si les conditions sont optimales, un individu peut gagner entre 20% et 30% de masse maigre avec un cycle de 5 mois. Les premiers résultats ne se remarquent qu’après environ 2 mois d’utilisation.
Comment préparer mes injections ?
Tout d’abord nous vous conseillons l’HGH sous forme lyophilisée (poudre).
Pour la reconstitution, il existe différents diluants. L’eau bactériostatique stérile (0.9% de chlorure de sodium), de l’eau saline (0.9% NaCl) ou de l’eau stérile simple pour l’injection. N’importe laquelle d’entre elles fonctionneront mais si possible, utilisez de l’eau stérile.
Les seringues de type insuline sont les plus recommandées tant pour le mélange que pour l’injection.
Retirez le bouchon en plastique du flacon et nettoyez l’élastique avec un coton d’alcool médical. Prenez une seringue de type insuline et prenez 1 ml d’eau que vous transvaserez à l’intérieur du vial d’HGH. Poussez l’aiguille à travers le bouchon élastique du flacon, mais positionnez-la de côté pour que l’eau coule le long de la paroi du flacon. N’injectez pas directement l’eau dans la poudre avec force, laissez la plutôt couler doucement.
N’agitez pas le flacon.
L’injection se fait en sous cutané dans la graisse de la peau du ventre. Une zone différente doit être utilisée pour chaque injection (pour éviter d’entraîner de potentiels trous dans la graisse du corps – comme le HGH est connu pour promouvoir la diminution de la graisse localement).

Conclusion
Vous avez maintenant toutes les cartes en mains pour maîtriser, composer et surtout réussir votre prochaine cure d’hormone de croissance et ce, quel que soit votre objectif.
Comme d’habitude, toute l’équipe upsteroide.to est disponible pour vous conseiller et vous accompagner via livechat ou email.

Très intéressant, j’ai beaucoup appris a la lecture de cet article sur la somatropine
dans quel pays est-ce que je peux trouver de la hgh moins chère que la genotropin (200 euros le stylo de 16 iu ou 5,3 mg) comme dans certains pays de l’est ? car à ce prix-là pour prendre tous les jours pour une cure de trois mois…c’est inaccessible si je prend 4 stylo par semaine au moins.
Je vous dis clairement que les Hormones de Croissance Humaine sont l’avenir! Et on n’a pas encore tout vu, les chercheurs vont aller de découverte en découverte.